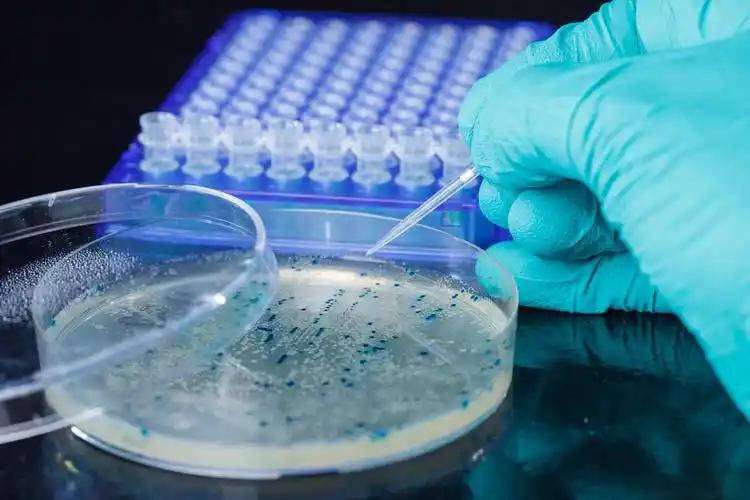
1757069518105722.jpg

清真产品中培养菌不能来源于动物:合规性分析与认证要求
清真认证中关于培养菌来源的基本要求
清真认证要求产品及其生产过程完全符合伊斯兰教法规定。对于培养菌而言,其来源、培养基成分及整个生产过程都不能涉及任何伊斯兰教禁忌的物质。
禁止使用动物源菌种:尤其是来自猪、未清真屠宰的动物或其衍生物的菌种。
允许使用非动物源菌种:如植物源、微生物自源或清真认证的动物源菌种(需符合严格屠宰规范)。
培养基是培养菌生长的基础,其成分的清真合规性至关重要:
蛋白胨:这是一个需要特别注意的高风险成分。很多蛋白胨(包括胰蛋白酶蛋白胨)在生产过程中使用了猪胰腺提取的酶(如胰蛋白酶)来降解蛋白质。即使最终产品中检测不到猪源成分,这种使用猪源酶加工过的蛋白胨也被清真认证机构视为非清真。
非动物源成分:一般认为植物源、合成化学源的成分风险较低,但仍需确保其生产过程中未接触非清真物质。
替代方案
植物源培养基:使用植物源,如木薯、玉米发酵,使用大豆、小麦等植物蛋白替代动物血清。
合成培养基:采用化学定义的培养基(如氨基酸、维生素混合物)。
基因工程菌种:通过基因改造微生物(如大肠杆菌、酵母菌)生产所需酶或代谢产物,需确保菌株本身无动物源成分。
培养菌来源的合规性分析
培养菌/培养基来源 | 清真合规性 | 关键原因与注意事项 |
动物源(非清真屠宰) | 明确禁止 | 来源于未按伊斯兰教法屠宰的动物,或其任何衍生物(如某些胰蛋白酶、牛肉膏、血清)。 |
动物源(清真屠宰) | 有条件允许 | 必须提供清真认证证书,证明动物来源及屠宰过程符合教法。但仍需注意某些保守派学者或标准可能不完全接受。 |
植物源 | 普遍接受 | 大豆蛋白胨、小麦提取物等植物来源成分风险较低,通常被认为是清真的。但仍需审核整个生产过程,避免交叉污染。 |
合成化学源 | 普遍接受 | 化学合成的培养基成分(如限定培养基中的特定化学成分)通常被认为是清真的,前提是合成过程中未使用任何非清真的催化剂或原料。 |
微生物源 | 普遍接受 | 从清真合规的微生物中提取的成分(如酵母浸粉、酵母提取物)通常被认为是可接受的,但同样需要确认其生产流程和培养基的清真性。 |
实践建议与注意事项
源头管理,优先选择认证原料:
在选择培养菌和培养基时,优先考虑已获得权威清真认证的产品。向供应商明确要求提供清真证书(Halal Certificate)。
对于关键原料(如蛋白胨、酵母浸粉),应追溯到其最原始的来源和加工工艺,确认其酶解过程未使用猪源酶。
全面评估供应链:
清真合规性关乎整个供应链。不仅要确保自己生产过程合规,还需确保供应商、乃至供应商的供应商都符合清真要求。
引入新原料供应商时,必须事先经过认证机构的审核和批准,不可擅自更换。
生产过程中的隔离与防污染:
设备专用:理想情况下,生产清真产品的设备应专用。如果无法实现,在生产清真产品前,必须对设备进行严格的清洗和清真化处理。
严格隔离:在仓储和运输过程中,必须确保清真原料与非清真原料物理隔离,防止交叉污染。
注意“隐性”风险:
加工助剂:一些加工助剂(如过滤用的明胶、脱色用的骨炭、设备润滑剂)也可能含有动物成分,需要同样关注。
酒精消毒:在生产区域,避免使用酒精进行消毒,因为酒精是清真禁忌物。可使用其他符合规定的消毒剂替代。
随着全球清真市场的不断扩大和标准化的推进,相关的要求和检测技术也会越来越完善。对于企业而言,主动了解并严格遵守这些要求,不仅是进入清真市场的通行证,更是对穆斯林消费者宗教信仰的尊重。

湖南赛罗克,印尼官方清真 Halal 认证直属授权,国际清真机构中国独家代理,
千类产品综合认证解决方案专家,助力企业进入全球20亿人口清真市场;
涵盖:印尼官方 BPJPH 清真认证、印尼 MUl清真认证、马来西亚
官方 JAKIM 清真认证、美国 IFANCA 清真认证。
服务企业部分名录:




